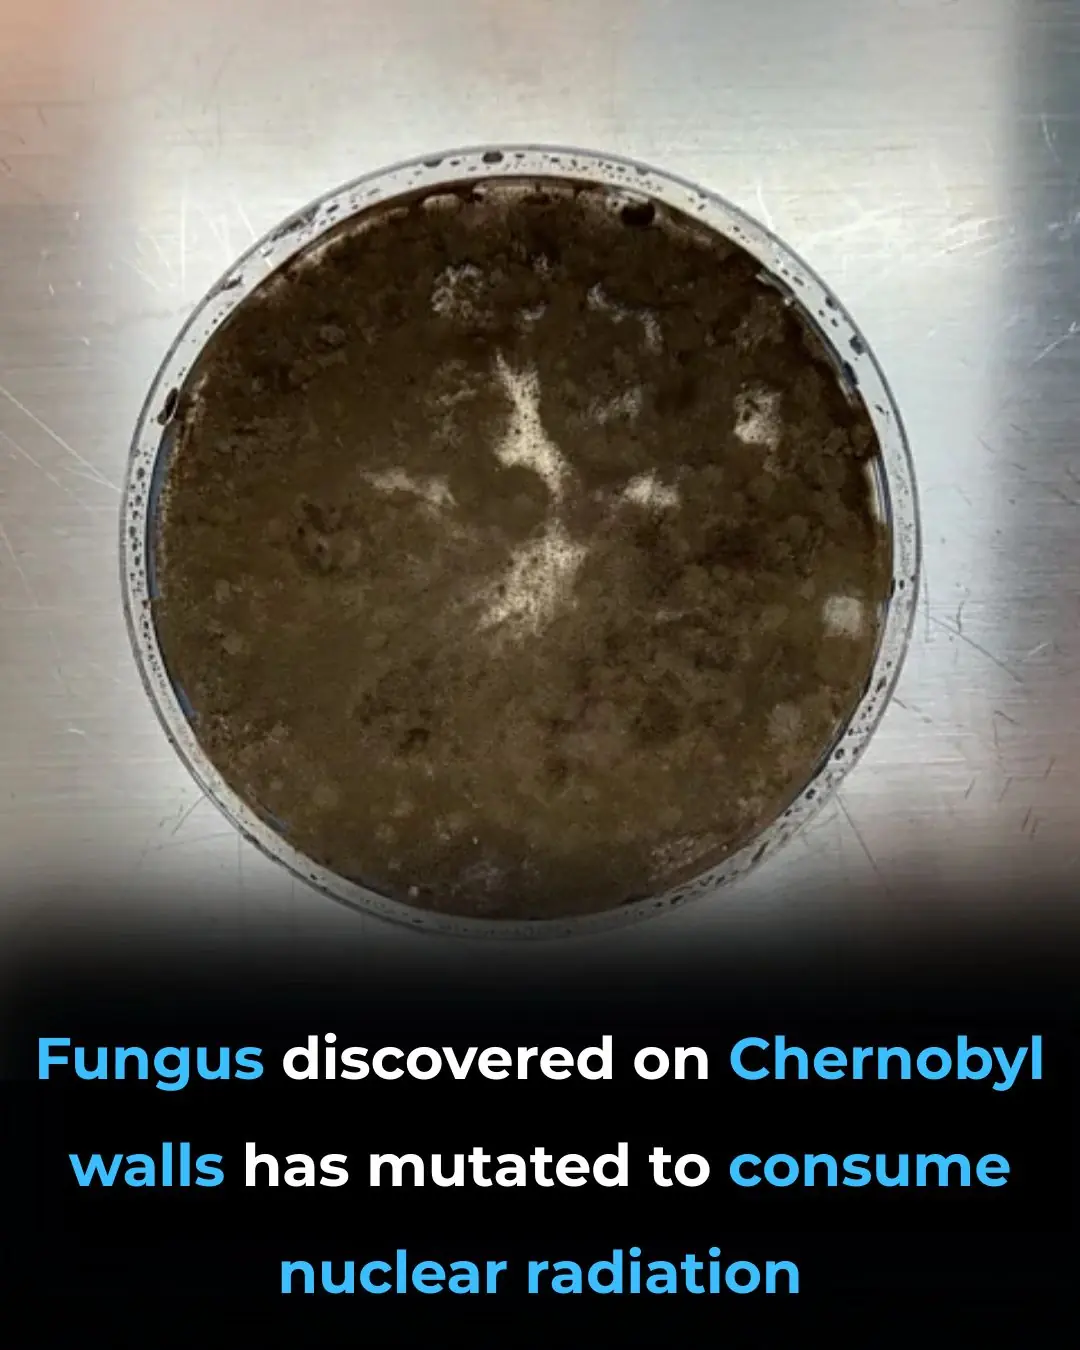

The Fungus That Eats Radiation — And May Help Humans Survive in Space
Deep within the abandoned, radioactive remains of Chernobyl, scientists stumbled upon one of nature’s strangest survivors — a black fungus that doesn’t just withstand radiation… it feeds on it.
This organism, Cladosporium sphaerospermum, has stunned researchers for decades. Unlike most life forms that suffer damage when exposed to ionizing radiation, this fungus appears to grow faster in high-radiation environments. Its secret weapon? Melanin — the same pigment that colors human skin, but used here in an entirely different way.
A Fungus That Turns Radiation Into Energy
Cladosporium sphaerospermum is packed with melanin, and scientists believe this pigment acts like a biological solar panel.
But instead of absorbing sunlight, the fungus absorbs ionizing radiation — the harmful, high-energy radiation found in nuclear environments and outer space.
This process is known as radiosynthesis.
If photosynthesis converts sunlight into chemical energy, radiosynthesis converts radiation into the biological equivalent of fuel. The fungus essentially “eats” radiation, using it to power its growth.
This remarkable adaptation was first noticed after the Chernobyl disaster. Black, melanin-rich fungi were seen growing on the walls of the Reactor 4 ruins — in places where radiation levels were far too high for humans.
A Strange Discovery with Extraordinary Potential
The fungus was first documented in 1991. But from 2007 onward, researchers began to examine it in detail — and the results were astonishing.
Key scientific findings include:
-
The fungus grows faster in radiation-rich environments than in normal conditions.
-
Melanin changes its electronic structure when exposed to radiation, increasing its ability to absorb energy.
-
Radiation seems to enhance the fungus’s metabolic activity, similar to how light increases the activity of photosynthetic organisms.
These findings led scientists to consider extraordinary possibilities — particularly for environments where humans struggle to survive.
From Chernobyl to the International Space Station
Scientists eventually sent samples of the fungus to the International Space Station (ISS) to see how it behaved in microgravity combined with cosmic radiation.
The results surprised even the researchers:
-
The fungus grew rapidly despite the harsh space environment.
-
A thin layer of it actually reduced radiation levels behind it.
-
It demonstrated the potential to act as a self-healing, self-replicating radiation shield.
This makes Cladosporium sphaerospermum one of the most promising biological tools for future space exploration.
Future Applications: Earth and Beyond
Because of its unusual abilities, the fungus may one day play an important role in both environmental cleanup and space travel.
1. Cleaning Up Nuclear Waste Sites
Radiation-loving fungi could help:
-
Break down radioactive materials
-
Reduce radiation levels in contaminated regions
-
Assist in bioremediation at hazardous sites like Fukushima and Chernobyl
Instead of using costly machinery, we may someday use living organisms to clean environments humans cannot enter.
2. Protecting Astronauts in Deep Space
Cosmic radiation is one of the biggest threats to missions to Mars and beyond. Traditional shielding is heavy and expensive to launch.
But a thin layer of melanin-rich fungus could:
-
Absorb radiation
-
Regenerate itself
-
Repair damaged areas automatically
-
Grow using the very radiation it protects astronauts from
Imagine spacecraft or Mars habitats coated in a living, self-sustaining radiation shield.
3. Engineering Melanin-Based Materials
Researchers are exploring whether melanin could be extracted or engineered to create:
-
Lightweight radiation-blocking tiles
-
Protective coatings
-
New biocompatible shielding materials
Nature may provide solutions more efficient than anything humans have designed so far.
From a Nuclear Ruin to a Beacon of Hope
What started as a strange observation in the ruins of Chernobyl has grown into one of the most exciting discoveries in modern biology. A simple black fungus — thriving where life has no business surviving — may offer answers to some of humanity’s biggest challenges:
-
How to clean our most toxic environments
-
How to protect astronauts traveling far beyond Earth
-
How to build sustainable habitats on Mars or other planets
The fungus that “eats” radiation reminds us that evolution can produce unimaginable solutions — and sometimes, the smallest organisms teach us the biggest lessons.
What once seemed like a weird survivor in a nuclear wasteland…
may soon help humanity thrive among the stars. 🚀
News in the same category


Doctors in the U.S. reveal how to eliminate pesticides and dirt from your fruits — just a few simple steps can protect your whole family

You’re thawing your meat the wrong way. These 4 common methods are actually breeding grounds for bacteria — and can make your whole family sick

You’re drinking the wrong thing. Here’s the “golden drink” that protects your heart — especially if you sit all day

Can a Tea Bag Really Keep Mice and Spiders Away

Why are some window bars curved at the bottom

It’s time to SAVE YOUR LIVER by cutting out these 5 everyday vegetables that can silently cause serious harm

Most folks mess this up. The right way to grow clematis on a trellis

I had no idea this tiny fabric square had such an important purpose

You’re Handling Motion Sickness All Wrong. Here Are 8 Instant Ways to Beat It Without Medicine

You’re Doing It All Wrong: The Proper Way to Store Leftovers

From Rain to Runway: How Singapore’s Changi Airport Saves Over 8 Million Gallons of Water a Year

Rising Tide of Change: The World’s Coastlines Are Entering a New Era

The Girl Who Said No — And Changed a Nation Forever

Fresh Trump Approval Poll Shows What

Say Goodbye to Swelling

8 Instant, Medicine-Free Ways to Relieve Motion Sickness: Travel Comfortably on Any Trip

Doctors Warn: 9 Dangerous Food Pairings That May Produce Toxins or Increase Long-Term Health Risks

7 Foods That Don’t Spoil Easily: Safe to Eat Even After the “Expiration Date”
News Post

Silent Kidney Disease: Symptoms, Causes, and Prevention Tips

When boiling duck, don't add ginger and cold water: Add this and the meat will lose all its stench, and you won't get tired of eating it.

How to make steamed chicken with lemongrass, golden brown chicken, soft and delicious, irresistible

Simple tips to help reduce itching extremely quickly when bitten by mosquitoes and insects

10 Warning Signs of Heart Disease Most People Ignore

How to wash and condition hair with rice water to reduce hair loss and help new hair grow continuously

A Medical Miracle From Japan: How Stem Cells Helped a Paralyzed Man Walk Again

Shocking Truth About How Crabsticks Are Made

How This Traditional Korean Dish Helped Immune Cells Spot Viruses Without Overreacting

How Siblings Can Grow Up in the Same Home but Live Completely Different Childhoods

Doctors reveal that eating beets causes...

Understanding Liver Damage: Stages, Causes, and How to Prevent It

Kaaba’s Radiant Glow Seen from Space: A Celestial Spotlight on Islam’s Holiest Site

Scientific Breakthroughs in Women's Health: How Research is Finally Addressing Gender Gaps

Monkeys, Money, and Unexpected Behavior: Insights from a 2005 Yale Study on Capuchin Monkeys and Economic Decision-Making

How Europe's Skin Pigmentation Evolved: Dark to Light Over Millennia

Bamboo and Hemp: Sustainable Solutions for a Greener, Plastic-Free Future

People with heart problems should avoid these 4 things to reduce stimulation to the heart
